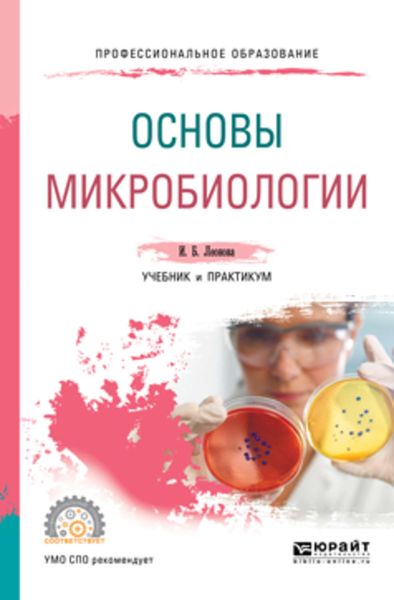
Основы микробиологии. Учебник и практикум для СПО

Книги серии «Профессиональное образование»

Право социального обеспечения 3-е изд., пер. и доп. Учебник и практикум для СПО
Владимир Шамильевич Шайхатдинов

Технология меха: специальные главы 2-е изд., испр. и доп. Учебное пособие для СПО
Ильдар Шаукатович Абдуллин

Искусство фортепианного интонирования 2-е изд., испр. и доп. Учебник для СПО
Августа Викторовна Малинковская

Теория и методика социальной работы 2-е изд., пер. и доп. Учебник для СПО
Ирина Андреевна Григорьева

Методика обучения творческому чтению 2-е изд., испр. и доп. Учебное пособие для СПО
Наталия Николаевна Светловская

Сопротивление материалов. Руководство к решению задач в 2 ч. Часть 1 4-е изд., испр. и доп. Учебное пособие для СПО
Леонид Сергеевич Минин

Физика. Механика. Электромагнетизм 2-е изд., испр. и доп. Учебное пособие для СПО
Владимир Иннокентьевич Бабецкий

Хоровой класс и практическая работа с хором 2-е изд., испр. и доп. Учебное пособие для СПО
Владимир Аркадьевич Самарин

Теоретические и методические основы организации различных видов деятельности детей. Туризм в детском саду 2-е изд., испр. и доп. Учебное пособие для СПО
Татьяна Павловна Завьялова

Практическая логика: задачи и упражнения 2-е изд., испр. и доп. Учебное пособие для СПО
Александр Архипович Ивин

Фортепианно-исполнительское интонирование. Методики XVI-XX веков 2-е изд., испр. и доп. Учебное пособие для СПО
Августа Викторовна Малинковская

Основы оптики. Теория изображения 2-е изд., испр. и доп. Учебное пособие для СПО
Игорь Иванович Суханов

Общая физика в 2 т. Том 2 2-е изд., испр. и доп. Учебное пособие для СПО
Геннадий Алексеевич Бордовский

Теория вероятностей и математическая статистика 2-е изд., испр. и доп. Учебник и практикум для СПО
Альберт Афанасьевич Васильев

Технология машиностроения. Обработка ответственных деталей. Учебное пособие для СПО
Александр Александрович Черепахин

Общая физика в 2 т. Том 1 2-е изд., испр. и доп. Учебное пособие для СПО
Геннадий Алексеевич Бордовский

Математика: тригонометрические уравнения и неравенства 2-е изд., испр. и доп. Учебное пособие для СПО
Виктор Алексеевич Далингер